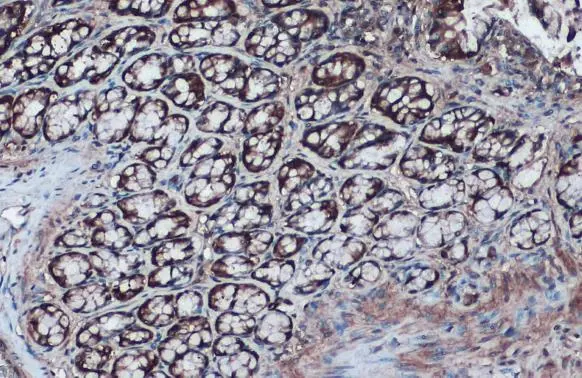
IDH1 antibody detects IDH1 protein at cytoplasm by immunohistochemical analysis. Sample: Paraffin-embedded rat colon. IDH1 stained by IDH1 antibody (GTX105179) diluted at 1:1000. Antigen Retrieval: Citrate buffer, pH 6.0, 15 min

IDH1 antibody detects IDH1 protein at cytoplasm by immunohistochemical analysis. Sample: Paraffin-embedded mouse intestine. IDH1 stained by IDH1 antibody (GTX105179) diluted at 1:1000. Antigen Retrieval: Citrate buffer, pH 6.0, 15 min
IDH1 antibody
GTX105179
ApplicationsImmunoPrecipitation, Western Blot, ImmunoHistoChemistry, ImmunoHistoChemistry Paraffin
Product group Antibodies
ReactivityHuman, Mouse, Rat
TargetIDH1
Overview
- SupplierGeneTex
- Product NameIDH1 antibody
- Delivery Days Customer9
- Application Supplier NoteWB: 1:1000-1:10000. IHC-P: 1:100-1:1000. IP: 1:100-1:1000. *Optimal dilutions/concentrations should be determined by the researcher.Not tested in other applications.
- ApplicationsImmunoPrecipitation, Western Blot, ImmunoHistoChemistry, ImmunoHistoChemistry Paraffin
- CertificationResearch Use Only
- ClonalityPolyclonal
- Concentration2.33 mg/ml
- ConjugateUnconjugated
- Gene ID3417
- Target nameIDH1
- Target descriptionisocitrate dehydrogenase (NADP(+)) 1
- Target synonymsHEL-216, HEL-S-26, IDCD, IDH, IDP, IDPC, PICD, isocitrate dehydrogenase [NADP] cytoplasmic, NADP(+)-specific ICDH, NADP-dependent isocitrate dehydrogenase, cytosolic, NADP-dependent isocitrate dehydrogenase, peroxisomal, epididymis luminal protein 216, epididymis secretory protein Li 26, epididymis secretory sperm binding protein, isocitrate dehydrogenase (NADP(+)) 1, cytosolic, isocitrate dehydrogenase 1 (NADP+), soluble, oxalosuccinate decarboxylase
- HostRabbit
- IsotypeIgG
- Protein IDO75874
- Protein NameIsocitrate dehydrogenase [NADP] cytoplasmic
- Scientific DescriptionIsocitrate dehydrogenases catalyze the oxidative decarboxylation of isocitrate to 2-oxoglutarate. These enzymes belong to two distinct subclasses, one of which utilizes NAD(+) as the electron acceptor and the other NADP(+). Five isocitrate dehydrogenases have been reported: three NAD(+)-dependent isocitrate dehydrogenases, which localize to the mitochondrial matrix, and two NADP(+)-dependent isocitrate dehydrogenases, one of which is mitochondrial and the other predominantly cytosolic. Each NADP(+)-dependent isozyme is a homodimer. The protein encoded by this gene is the NADP(+)-dependent isocitrate dehydrogenase found in the cytoplasm and peroxisomes. It contains the PTS-1 peroxisomal targeting signal sequence. The presence of this enzyme in peroxisomes suggests roles in the regeneration of NADPH for intraperoxisomal reductions, such as the conversion of 2, 4-dienoyl-CoAs to 3-enoyl-CoAs, as well as in peroxisomal reactions that consume 2-oxoglutarate, namely the alpha-hydroxylation of phytanic acid. The cytoplasmic enzyme serves a significant role in cytoplasmic NADPH production. [provided by RefSeq]
- ReactivityHuman, Mouse, Rat
- Storage Instruction-20°C or -80°C,2°C to 8°C
- UNSPSC41116161